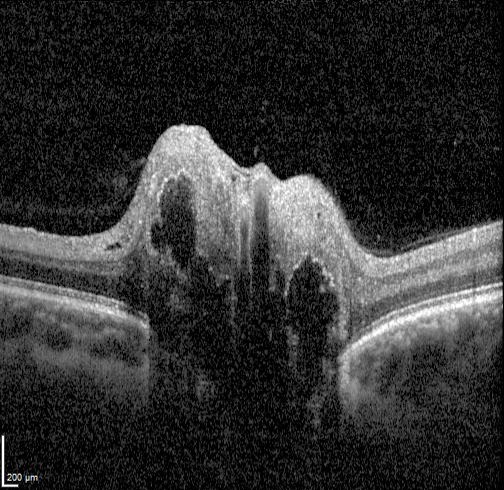

Overview
Optic nerve head drusen are calcified deposits located anterior to the lamina cribosa. They are thought to occur by a combination of factors including a disturbance of metabolism in the axons, abnormal vasculature and a small scleral canal.
The clinical appearance varies depending on the depth of the deposits as they may initially be buried within the nerve but migrate slowly towards the surface of the optic nerve and become superficial. The diagnosis is relatively straightforward when the disc drusen are superficial (approximately 60% of cases), however buried disc drusen can create an elevated optic disc appearance and mimic disc swelling (pseudopapilloedema).
Patients with optic nerve head drusen are usually asymptomatic although symptoms of transient visual obscurations can occur. In contrast, true papilloedema may be associated with numerous symptoms including but not limited to nausea, vomiting, headaches, diplopia, tinnitis and transient vision loss.
Superficial disc drusen appear as round, refractile deposits on the surface of the optic nerve. They may vary in size and often appear in clusters. Fundus autofluorescence imaging shows hyper-autofluoresescence of the drusen, and is a key diagnostic test for this condition. Buried disc drusen may not be easily visualised on fundus examination or fundus autofluorescence and in these cases, a B-scan ultrasound is useful as the calcific component of the drusen causes them to appear hyper-echoic when imaged.
On OCT imaging, drusen appear as hyporeflective bodies with hyperreflective margins. Enhanced depth imaging (EDI) is useful to improve visualisation of buried drusen. However, in cases where the drusen is deeply buried, they may not be visible on OCT.
Optic nerve head drusen can cause compression and damage to the retinal nerve fibres with RNFL thinning seen on OCT. Associated visual field defects can also occur and may be variable depending on the location of the drusen and area of RNFL damage. Visual field defects include arcuate defects, enlarged blindspots, nasal steps and peripheral constriction.
Case Examples
-
Case 1: Surfaced ONH drusen
A 43 year old asymptomatic Caucasian female with best corrected visual acuity of 6/6 (20/20) in each eye.
Disc photos and fundus autofluorescence (right and left eye)
More infoRed free images (right and left eye)
More infoSpectralis OCT line scans (right optic disc)
More infoSpectralis OCT line scans (left optic disc)
More infoB-scan ultrasound (right and left eye)
More infoCirrus RNFL Analysis
More infoCirrus Ganglion Cell Analysis
More info24-2 SITA Faster visual field
More info -
Case 2: Surfaced ONH drusen
A 29 year old Caucasian male with best corrected visual acuity of 6/6 (20/20) in each eye.
Disc photos and fundus autofluorescence images (right and left disc)
More infoRed free images (right and left eye)
More infoB-scan ultrasound (right and left eye)
More infoSpectralis OCT line scans - Right (1) and Left (2) optic disc
More infoCirrus RNFL Analysis
More info30-2 SITA Standard visual field
More info -
Case 3: Extensive surfaced drusen
A 24 year old Indian male with best corrected visual acuity of 6/6 (20/20) in each eye.
Fundus photograph and red-free image (right eye)
More infoFundus photograph and red-free image (left eye)
More infoMagnified view of the right and left optic nerve heads
More infoFundus autofluorescence imaging
More infoSpectralis OCT line scan through the right optic disc
More infoSpectralis OCT line scan through the left optic disc
More infoCirrus RNFL analysis
More infoCirrus Ganglion Cell Analysis
More info24-2 Humphrey visual field test (SITA-faster)
More info -
Case 4: Buried ONH drusen
A 58 year old asymptomatic Caucasian female with best corrected visual acuity of 6/6 (20/20) in each eye.
Disc photos and fundus autofluorescence images (right and left eye)
More infoSpectralis OCT volume and line scan (right optic disc)
More infoSpectralis OCT line scan (left optic disc)
More infoB-scan ultrasound (right and left eye)
More infoCirrus RNFL Analysis
More info24-2 SITA Faster visual field
More info -
Case 5: Progression of ONH drusen
An 8 year old asymptomatic Caucasian female was followed for a period of 3 years. This case will present clinical findings from her initial visit and from the most recent visit 3 years later.
Optic disc photos and fundus autofluorescence imaging (right and left eye)
More infoFlicker comparison of discs at initial and follow-up visits
More infoFlicker comparison of fundus autofluorescence imaging (initial and follow up)
More infoFlicker comparison of red free images - initial and follow up (right and left eye)
More infoSpectralis OCT line scans at initial and follow-up visits (right eye)
More infoSpectralis OCT line scans at initial and follow-up visits (left eye)
More infoCirrus RNFL guided progression analysis (right eye)
More infoCirrus RNFL Guided Progression Analysis (left eye)
More info -
Case 6: Stable optic neuropathy secondary to ONH drusen
A 68 year old female presented for an optic nerve assessment in 2022, then was reviewed every 6 months until 2024. VA was 6/7.5-2 (OD) and 6/9.5 (OS) – no improvement with pinhole, and IOP was 7mmHg in the right eye and 8mmHg in the left.
Fundus photograph (right and left eye)
More infoRed-free images (right and left eye)
More infoStereophoto of the right optic disc
More infoStereophoto of the left optic disc
More infoFundus autofluoresence (FAF) Imaging
More infoCirrus Ganglion Cell Analysis (GCA)
More infoCirrus RNFL anlaysis
More infoHumphrey 30-2 threshold visual field
More infoHumphrey 20-2 threshold visual field
More infoCirrus OCT Angiography
More infoCirrus Guided Progression Analysis - GCIPL
More infoCirrus Guided Progression Analysis - RNFL
More infoHumphrey Visual Field Guided Progression Analysis
More info
Differential diagnosis
References
Arturo Carta, Stefania Favilla, Marco Prato, Stefania Bianchi-Marzoli, Alfredo A. Sadun, Paolo Mora; Accuracy of Funduscopy to Identify True Edema versus Pseudoedema of the Optic Disc. Invest. Ophthalmol. Vis. Sci. 2012;53(1):1-6.
Chiang, J., Wong, E., Whatham, A., Hennessy, M., Kalloniatis, M. and Zangerl, B. (2015), Differentiating optic nerve head swelling. Clin Exp Optom, 98: 12-24
Palmer, E., Gale, J., Crowston, J. G., & Wells, A. P. (2018). Optic Nerve Head Drusen: An Update. Neuro-ophthalmology (Aeolus Press), 42(6), 367–384.